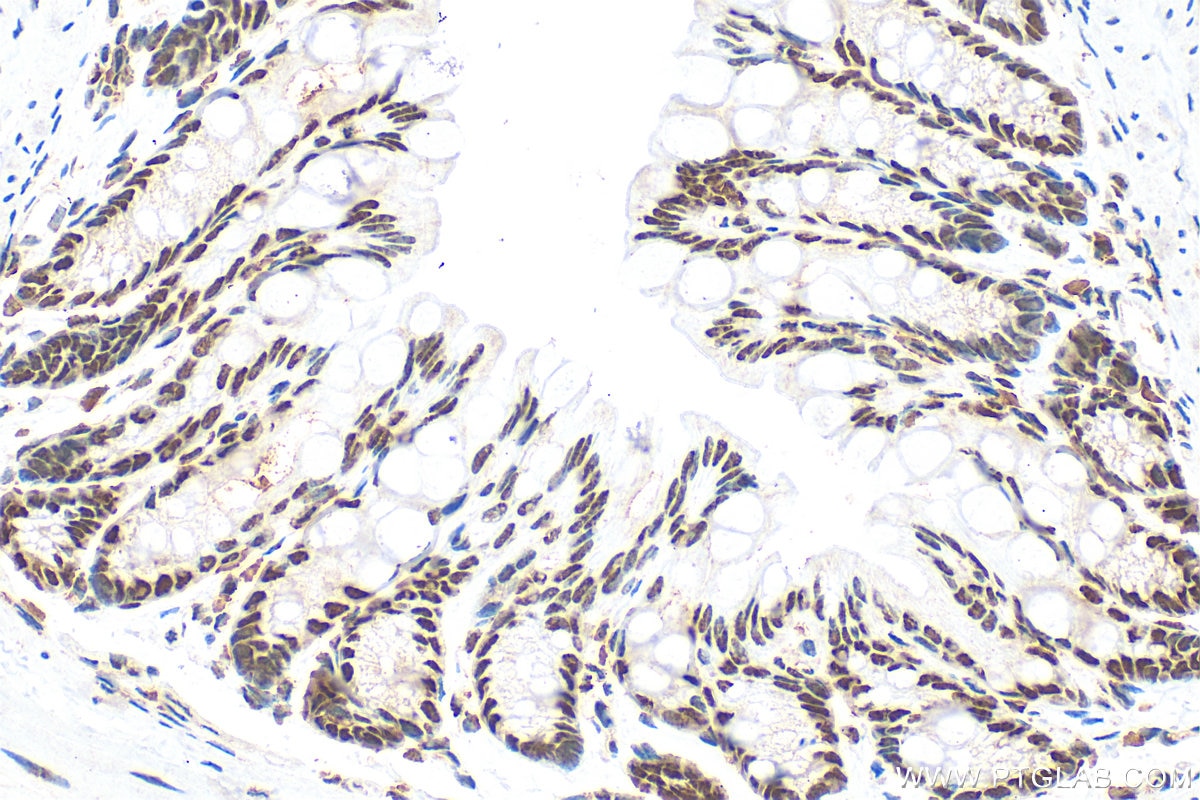
Immunohistochemistry (IHC) staining of mouse colon tissue using Sam68 Polyclonal antibody (10222-1-AP)
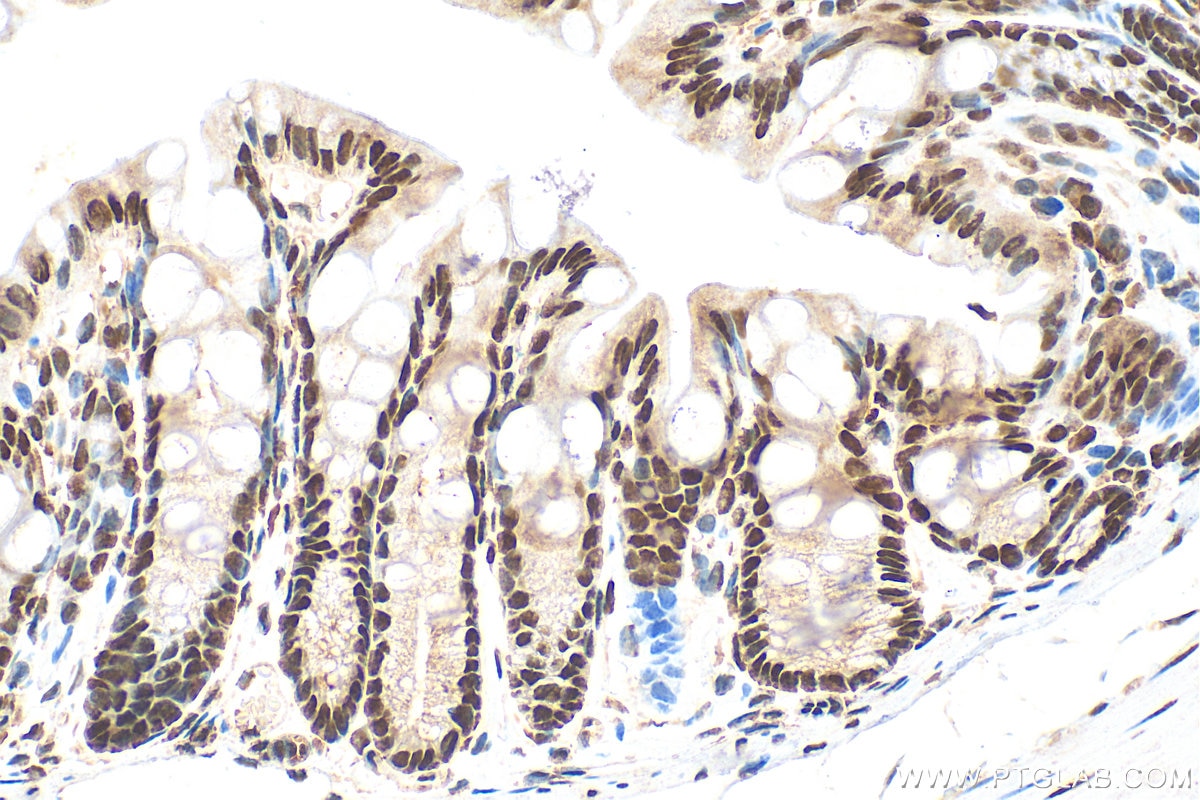
Immunohistochemistry (IHC) staining of mouse colon tissue using Sam68 Polyclonal antibody (10222-1-AP)

Tested Applications
| Positive WB detected in | HEK-293 cells, HeLa cells, HT-29 cells, mouse brain tissue, NIH/3T3 cells, mouse embryo tissue, rat brain tissue |
| Positive IP detected in | HeLa cells |
| Positive IHC detected in | human breast cancer tissue, mouse colon tissue Note: suggested antigen retrieval with TE buffer pH 9.0; (*) Alternatively, antigen retrieval may be performed with citrate buffer pH 6.0 |
| Positive IF/ICC detected in | HepG2 cells |
Recommended dilution
| Application | Dilution |
|---|---|
| Western Blot (WB) | WB : 1:2000-1:10000 |
| Immunoprecipitation (IP) | IP : 0.5-4.0 ug for 1.0-3.0 mg of total protein lysate |
| Immunohistochemistry (IHC) | IHC : 1:20-1:200 |
| Immunofluorescence (IF)/ICC | IF/ICC : 1:50-1:500 |
| It is recommended that this reagent should be titrated in each testing system to obtain optimal results. | |
| Sample-dependent, Check data in validation data gallery. | |
Published Applications
| KD/KO | See 1 publications below |
| WB | See 10 publications below |
| IHC | See 4 publications below |
| IP | See 1 publications below |
| CoIP | See 1 publications below |
| RIP | See 2 publications below |
Product Information
10222-1-AP targets Sam68 in WB, IHC, IF/ICC, IP, CoIP, RIP, ELISA applications and shows reactivity with human, mouse, rat samples.
| Tested Reactivity | human, mouse, rat |
| Cited Reactivity | human, mouse |
| Host / Isotype | Rabbit / IgG |
| Class | Polyclonal |
| Type | Antibody |
| Immunogen |
CatNo: Ag0235 Product name: Recombinant human Sam68 protein Source: e coli.-derived, PGEX-4T Tag: GST Domain: 201-442 aa of BC000717 Sequence: GSMRDKAKEEELRKGGDPKYAHLNMDLHVFIEVFGPPCEAYALMAHAMEEVKKFLVPDMMDDICQEQFLELSYLNGVPEPSRGRGVPVRGRGAAPPPPPVPRGRGVGPPRGALVRGTPVRGAITRGATVTRGVPPPPTVRGAPAPRARTAGIQRIPLPPPPAPETYEEYGYDDTYAEQSYEGYEGYYSQSQGDSEYYDYGHGEVQDSYEAYGQDDWNGTRPSLKAPPARPVKGAYREHPYGR Predict reactive species |
| Full Name | KH domain containing, RNA binding, signal transduction associated 1 |
| Calculated Molecular Weight | 48 kDa |
| Observed Molecular Weight | 68 kDa |
| GenBank Accession Number | BC000717 |
| Gene Symbol | Sam68 |
| Gene ID (NCBI) | 10657 |
| RRID | AB_2130292 |
| Conjugate | Unconjugated |
| Form | Liquid |
| Purification Method | Antigen affinity purification |
| UNIPROT ID | Q07666 |
| Storage Buffer | PBS with 0.02% sodium azide and 50% glycerol, pH 7.3. |
| Storage Conditions | Store at -20°C. Stable for one year after shipment. Aliquoting is unnecessary for -20oC storage. 20ul sizes contain 0.1% BSA. |
Background Information
KHDRBS1, also named as SAM68, p62and p68, belongs to the KHDRBS family. It is recruited and tyrosine phosphorylated by several receptor systems, for example the T-cell, leptin and INS receptors. Once phosphorylated, KHDRBS1 functions as an adapter protein in signal transduction cascades by binding to SH2 and SH3 domain-containing proteins. It represses CBP-dependent transcriptional activation apparently by competing with other nuclear factors for binding to CBP. KHDRBS1 also acts as a putative regulator of mRNA stability and/or translation rates and mediates mRNA nuclear export. KHDRBS1 has three isoforms with calculated MW of 44-48kd. For isoform with a calculated MW of 48.2 kD, it migrated as a 68kD protein on SDS-PAGE gels[PMID: 10564820]. This ia a rabbit polyclonal antibody raised against residues near the N terminus of human Sam68.
Protocols
| Product Specific Protocols | |
|---|---|
| IF protocol for Sam68 antibody 10222-1-AP | Download protocol |
| IHC protocol for Sam68 antibody 10222-1-AP | Download protocol |
| IP protocol for Sam68 antibody 10222-1-AP | Download protocol |
| WB protocol for Sam68 antibody 10222-1-AP | Download protocol |
| Standard Protocols | |
|---|---|
| Click here to view our Standard Protocols |
Publications
| Species | Application | Title |
|---|---|---|
Acta Neuropathol Transportin 1 accumulates specifically with FET proteins but no other transportin cargos in FTLD-FUS and is absent in FUS inclusions in ALS with FUS mutations. | ||
Theranostics SAM68 promotes tumorigenesis in lung adenocarcinoma by regulating metabolic conversion via PKM alternative splicing. | ||
Mol Ther Nucleic Acids LRRC4 mediates the formation of circular RNA CD44 to inhibitGBM cell proliferation | ||
Reprod Fertil Dev Cold-induced RNA-binding protein (CIRBP) regulates the expression of Src-associated during mitosis of 68 kDa (Sam68) and extracellular signal-regulated kinases (ERK) during heat stress-induced testicular injury. |
Reviews
The reviews below have been submitted by verified Proteintech customers who received an incentive for providing their feedback.
FH Aleksandr (Verified Customer) (12-16-2024) | Excellent antibody for Sam68 detection in human cells!
![]() |
FH Tsimafei (Verified Customer) (11-19-2024) | Great antibody
![]() |
FH Julia (Verified Customer) (08-07-2024) | Used for 30ug of mESC. Many bands are visible with the thickest one at the correct size. Increasing the dilution should help to obtain cleaner picture.
![]() |